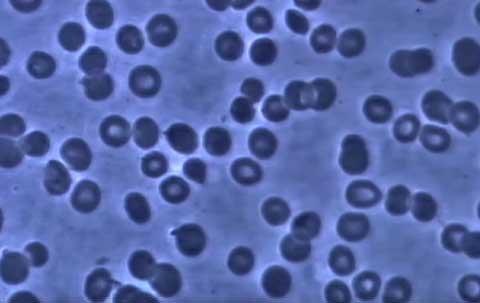

In our pursuit of science for life-changing impact, we collaborate on focused research programs to advance innovation quickly and effectively. Our research partners include academic institutions, foundations, government institutions, other biopharmaceutical companies and physicians — expanding the R&D ecosystem to better serve the needs of patients.
We are working on identifying the best scientific expertise across the globe, and we are actively engaging in partnerships to leverage that expertise in mutually beneficial ways. It is imperative that we stay on the leading edge of science to deliver the most impactful medicines and vaccines to patients in need.

Our collaboration with Spark Therapeutics, Inc., has entered the clinic, testing with human subjects a potential gene therapy, SPK-FIX, for the treatment of hemophilia B. The U.S. Food and Drug Administration has designated this therapy an Orphan Drug. The investigational therapy incorporates a bio-engineered Adeno-Associated Virus (AAV) vector — in practical terms, a carrier for therapeutic genes. Such vectors use a disarmed virus redesigned with the genetic instructions to produce a missing enzyme or therapeutic protein. Advances in the technology to harness disarmed viruses as gene delivery vehicles, coupled with increased understanding of the biology of hereditary rare diseases, provide a ripe opportunity to investigate the next wave of potential life-changing therapies for patients.
Our collaboration with 23andMe, Inc., a leading personal genetics company, enables us to study demographic and phenotypic data from nearly a million genotyped, de-identified individuals who have consented to participate in genetic research. Through this robust collaboration, we have been able to explore the links between genetic variation and disease phenotypes to identify new targets of potential therapeutic value. We believe this approach has strong potential for the future of drug discovery. In 2014, 23andMe and Pfizer combined forces to enroll 10,000 people with inflammatory bowel disease in a research initiative designed to explore the genetic factors associated with the onset, progression and severity of the disease, as well as response to treatments. In 2015, in a similar but more expansive effort, we collaborated with 23andMe to create a community for people with lupus, incorporating their medical records, genetic information and disease history to help better understand the etiology of the disease.

Pfizer has teamed up with longtime partner AARP and other health care innovators on an AARP-led program to help technology product
developers gain insights into how mature consumers use, or potentially could use, technology devices to improve and manage their
health — a unique opportunity to help inform the design and usability of future products. Project Catalyst — The Power of We
involves consumers aged 50+ in the innovation process by obtaining their feedback on product functionality and design as they
incorporate new technology into their daily lives. The first studies have focused on tracking activity and sleep using wearable
fitness trackers. Subsequent studies will focus on technology related to topics such as medication management and adherence,
caregiving needs, and behavioral and emotional health.
With the 50-plus population representing a large portion of the patients who depend on our medicines, we recognize the importance of finding innovative solutions to challenges such as medication management and adherence. Project Catalyst has the potential to enable collaboration across multiple stakeholder groups with the common goal of delivering valuable, innovative solutions.
Our Centers for Therapeutic Innovation (CTI) continue to build on an open innovation model for collaborating with academic researchers, foundations and the U.S. National Institutes of Health (NIH). CTI is designed to bridge the gap between early scientific discovery and its translation into new medicines, with Pfizer scientists working side by side with researchers from academia. Currently, CTI has 34 projects ongoing across five therapeutic areas.



CTI's collaboration with The Alzheimer's Drug Discovery Foundation (ADDF) is designed to advance the development of potential new drugs for Alzheimer's disease and related dementias. The collaboration allows investigators in CTI's academic network to submit research proposals to be considered by CTI, in collaboration with Pfizer's Neuroscience Research Unit and ADDF. Investigators whose proposals are selected receive joint funding from Pfizer and ADDF, as well as access to Pfizer's unrivaled drug discovery resources and ADDF's expertise in Alzheimer's disease research.
The Jeffrey Modell Foundation (JMF), a foundation that honors Jeffrey Modell, a boy who died of complications from an immunological disease, is collaborating with CTI to advance therapies for patients like Jeffrey. His parents, Vicki and Fred Modell, founded JMF to champion and facilitate early diagnosis, meaningful treatment and, ultimately, cures for immunological diseases.

Pfizer has expanded a lease agreement with a Massachusetts Institute of Technology subsidiary for the Kendall Square Research Facility, enabling us to consolidate our Cambridge research centers to create a single Pfizer Cambridge campus. This should allow for stronger collaborations in the Boston/Cambridge bioscience community and open new doors to unique partnerships, in the interest of expediting discovery and development efforts in this hub of life science innovation.
We continue to find creative ways to collaborate with innovators in biotech and biopharma that allow both sides to work together to accelerate the pace of innovation. This includes structuring relationships such that our collaborators are able to continue their efforts as they have been, but with access to resources of a leading, global health care company.
Pfizer acquired a minority equity interest in AM-Pharma B.V., a privately held Dutch biopharmaceutical company, and secured an exclusive option to acquire the remaining equity in the company. The arrangement allows the companies to leverage certain Pfizer resources that could potentially enable faster clinical development. AM-Pharma is focused on the development of recombinant human alkaline phosphatase (recAP) for inflammatory diseases — and is currently running a Phase 2 trial of recAP in the treatment of acute kidney injury related to sepsis. Pfizer's option becomes exercisable upon completion of the Phase 2 recAP trial, and until such time, AM-Pharma remains responsible for all aspects of the execution and analysis of the study. There are no drugs currently approved for this condition.
Pfizer has entered into a strategic drug discovery collaboration with Heptares Therapeutics to research and develop potential new medicines directed at up to ten G protein-coupled receptor (GPCR) targets across multiple therapeutic areas. Heptares will use its proprietary GPCR structure-guided platform to help deliver stabilized GPCRs (StaR® proteins), high resolution crystal structures and other technologies to support the discovery of potential novel agents directed to the GPCR targets selected by Pfizer. Pfizer will be responsible for developing and commercializing any potential therapeutic agents (small molecules or biologics derived from StaR technology) for each target and will have exclusive global rights to any potential resulting agents. Heptares is a wholly owned subsidiary of Sosei, a global biopharmaceutical company based in Japan. In addition to the collaboration agreement, our Japanese subsidiary Pfizer Seiyaku KK has made an equity investment in Sosei.
In August 2015, Orphan Drug status was granted by the U.S. Food and Drug Administration to GL-2045, a recombinant intravenous immuno-globulin mimetic licensed by Pfizer from Gliknik Inc., a privately held biopharmaceutical company, for the treatment of chronic inflammatory demyelinating polyneuropathy, a rare neurological disorder. The designation makes available numerous incentives to develop the autoimmune drug candidate to address an unmet need. As a recombinant (not blood derived) biologic, it is hoped that GL-2045 may eventually provide patients an alternative that is at least as effective as blood-derived intravenous immunoglobulin therapies that others are developing.
Pfizer and German biotech Evotec AG are collaborating to explore potential novel mechanisms for treating multi-organ fibrosis. The four-year license and collaboration agreement will see Evotec contribute its drug discovery platform while Pfizer will provide key technologies and industrial scope as well as pharmaceutical development and marketing expertise. Fibrosis is a non-physiological wound healing process that can lead to scarring and ultimately organ failure.